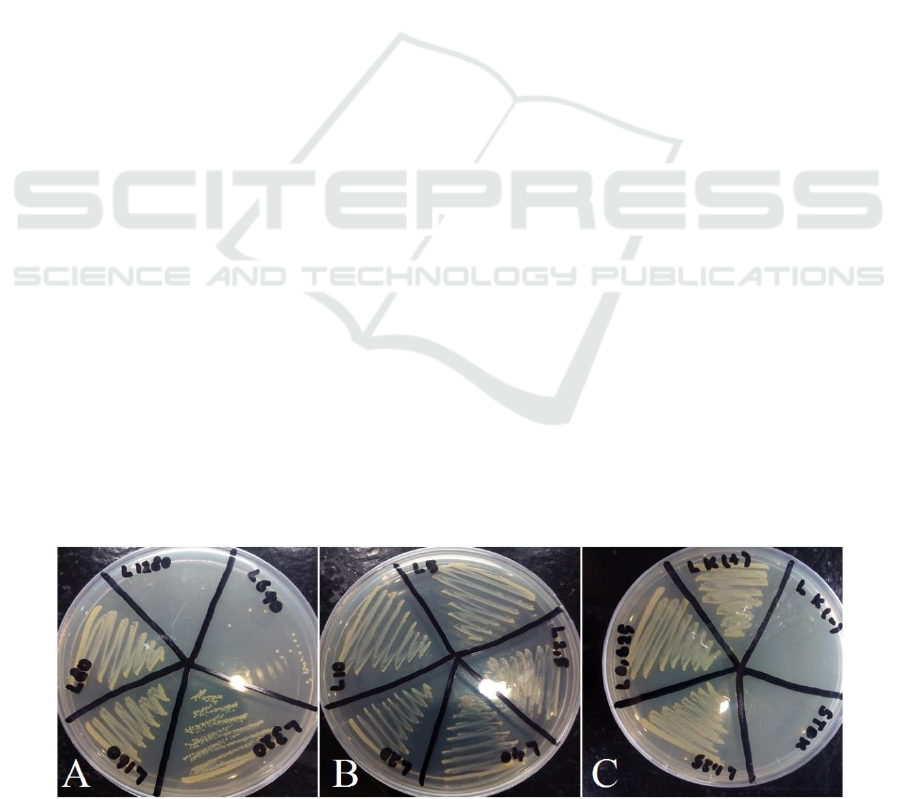

1
In Vitro Antibacterial Activity Test of Jackfruit (Artocarpus
heterophyllus Lam.) Leaf Extract against Methicillin-Resistant
Staphylococcus aureus (MRSA)
Ika Ningsih*
1
, Dyah Ayu Rosalinda
2
, Ariyani Kiranasari
1
, Beti Ernawati Dewi
1
, Fithriyah Sjatha
1
1
Department of Microbiology, Faculty of Medicine, Universitas Indonesia,
Jl. Pegangsaan Timur no. 16 Jakarta 10320
2
Undergraduate Program, Faculty of Medicine, Universitas Indonesia
Keywords: Antibacterial activity, jackfruit (Artocarpusheterophyllus Lam.) leaf extract, Methicillin-Resistant
Staphylococcus aureus (MRSA)
Abstract: Infectious diseases are still a public health problem in Indonesia. Methicillin Resistant Staphylococcus aureus
(MRSA) is one of bacteria causing infections that is a concern because of the nature of resistance to various
beta-lactam class of antibiotics. Therefore, it is necessary to find an alternative antibiotic for the treatment of
MRSA infections. This study aims to determine the antibacterial activity of jackfruit (Artocarpus
heterophyllus Lam.) leaf extract against MRSA by minimum inhibitory concentration (MIC) and minimum
bactericidal concentration (MBC) conducted using in-vitro test with broth macrodilution method. Jackfruit
(Artocarpus heterophyllus Lam.) leaf extract were used in half serial concentration of 1280 μg/ml to 0,625
μg/ml. MIC of jackfruit leaf extract against MRSA was found at concentration of 320 μg/ml which showed
by a clear solution in Brain Heart Infusion media. Meanwhile, MBC value of jackfruit leaf extract against
MRSA was found at concentration of 1280 μg/ml showed by the absence of MRSA colony growth Mueller-
Hinton agar. From this study showed that jackfruit (Artocarpus heterophyllus Lam.) leaf extract has anti-
bacterial activity against MRSA in-vitro.
1 INTRODUCTION
Until now infectious diseases are still a problem in
Indonesia (Ministry of Health, 2011; Mardiastuti et
al, 2007). One approach to manage infectious disease
is a rational antibiotic use which in Indonesia misuse
and overuse of antibiotics is commonly occur
(Mardiastuti et al, 2007). This phenomena can lead to
new problems of emerging antibiotic-resistant
microbial strains (Mardiastuti et al, 2007; National
Institute of Allergy and Infectious Diseases, 2015).
Methicillin-Resistant Staphylococcus aureus
(MRSA) is a strain of beta-lactam-resistant
Staphylococcus aureus, including penicillin,
oxacillin, methicillin, and so on (National Institute of
Allergy and Infectious Diseases, 2015) MRSA
resistance to various antibiotics is caused the
existence of genetic changes caused by the use of
antiobiotics irrationally (Nurkusuma D, 2009).
MRSA bacterial transmission is divided into 2
categories, namely Hospital-Acquired (through
medical measures such as catheterization or surgery)
and Community-Acquired (via direct contact with
patients or due to low levels of hygiene) (National
Institute of Allergy and Infectious Diseases, 2008).
MRSA bacterial infections may cause skin diseases
such as eczema, furuncle, impetigo, pyoderma, or
clinical manifestations of skin abscesses, venous
thrombosis, osteomyelitis or even dissemination
resulting in meningitis, pneumonia, endocarditis or
sepsis (Brooks GF et al, 2016) .
Data on the prevalence of MRSA infections in
Indonesia is limited. In 2003 the prevalence of MRSA
infections at Atmajaya Hospital Jakarta was recorded
at 47%, whereas in 2010 the incidence of MRSA
infection in Dr. Moh. Hoesin Palembang reached
46% (Yuwono, 2010). In 2013, research to find the
prevalence of MRSA infection was done in ICU and
surgical treatment room of RSUD Abdul Moeloek
Lampung and got prevalence rate 38,24%
(Mahmudah R, 2013). This relatively high prevalence
of multiresistant bacterial conditions is one of
particular concern as the choice of antibiotics therapy
Ningsih, I., Rosalinda, D., Kiranasari, A., Dewi, B. and Sjatha, F.
In Vitro Antibacterial Activity Test of Jackfruit (Artocarpus heterophyllus Lam.) Leaf Extract against Methicillin-Resistant Staphylococcus aureus (MRSA).
DOI: 10.5220/0009845300002406
In Proceedings of BROMO Conference (BROMO 2018) - Symposium on Natural Product and Biodiversity, page 1
ISBN: 978-989-758-347-6
Copyright
c
2022 by SCITEPRESS – Science and Technology Publications, Lda. All rights reserved
1

2
becomes more difficult. The drug of choice for the
treatment of MRSA infections is vancomycin, but
since 1996 MRSA has found a decreased sensitivity
to vancomycin (Yuwono, 2010). Even in 2002,
clinicians in the United States found a strain of
MRSA that was resistant to vancomycin (although the
numbers were few) (National Institute of Allergy and
Infectious Diseases, 2008).
Jackfruit (Artocarpus heterophyllus Lam.) is a
dicotyl plant with woody stems that are native to
India, Malaysia and Bangladesh, but can also grow
well in other tropical-subtropical regions including
Indonesia (Manuel NV et al, 2012; Orwa et al, 2009).
In addition to fruit, seeds, or young flowers are useful
as a source of food, other jackfruit plant parts are also
empirically often used as drugs. Jackfruit root is used
to treat skin diseases, asthma, fever, and diarrhea.
Jackfruit leaf is believed to cure ulcers. Jackfruit sap
is believed to cure abscesses, snake bites, and swollen
glands. While the seeds, often used to cure gall
disease (National Tropical Botanical Garden, 2015).
Several studies have been conducted to prove the
usefulness of jackfruit plants in the medical field. Jha
and Srivastava in his study found that jackfruit seed
oil could inhibit the growth of Escherichia coli,
Pseudomonas aeruginosa and Staphylococcus aureus
bacteria with minimum inhibitory concentrations
(MIC) between 1.55-5.20 mg / ml (Jha S et al, 2013).
Other studies have also shown the presence of
antibacterial activity from jackfruit extracts to MSSA
and MRSA played by the substance artocarpesin
(Manuel NV et al., 2012). Silver nanoparticles
synthesized from jackfruit leaf extracts have
antibacterial activity against Escherichia coli,
Staphylococcus aureus, Bacillus subtilis, Aspergillus
niger, and Pichia pastoris (Thombre R et al, 2012).
Testing of jackfruit leaf extracts on MRSA has not
been found.
In this study we investigate the ability of jackfruit
leaf extracts to inhibit MRSA growth by determining
its MIC (minimal inhibitory concentration) and MBC
(minimal bactericidal concentration).
2 MATERIAL AND METHODS
2.1 Preparation of extracts and MRSA
Bacteria
The extract was obtained from Indonesian Institute of
Sciences (LIPI) diluted in DMSO (Dimethyl
sulfoxide). MRSA bacteria originating from the
Microbiology Department Universitas Indonesia
culture collection which is stock in cryotube beads
and re-growth on blood agar followed by incubation
at 37
o
C for 18-24 hours. The growing bacteria were
identified with Gram staining and biochemical tests
using commercial products (Vitex).
2.2. Preparation of antibiotic and Jackfruit
leaf extract stock solutions
The vancomycin in powder form was diluted in
(Brain Heart Infusion) media to reach concentration
of 256 μg/ml. Meanwhile, Jackfruit leaf extract was
also diluted 10 times higher than vancomycin
concentration (2560 μg/ml).
2.2 Dilution of antibiotic and Jackfruit leaf
extract
Serial dilution of stock solution of antibiotics and
Jackfruit leaf extract were done using BHI media
until concentration of 0,25 μg/ml antbiotics and 2,5
μg/ml Jackfruit leaf extract were reached.
2.3 Determination of MIC (Minimum
Inhibitory Concentration)
Suspension of 0,5 McFarland value of MRSA
bacteria is inserted into each tube of BHI media
containing serial antibiotic and Jackfruit leaf extract
solution followed by incubation at 35°C-37°C for 24
hours. After that, an inspection was done on each tube
to assess the growth of bacteria characterized by
turbidity in the fluid in the tube. MIC value defiened
as the smallest extract concentration that inhibits
MRSA growth in BHI media.
2.4 Determination of MBC (Minimum
Bactericidal Concentration)
After MIC is known, 2 tubes at the lower and 2 tubes
at the higher concentration of MIC were subcultured
into Mueller-Hinton Agar (MHA) media followed by
incubation at 37
o
C for 24 hours. MBC value was
determined as concentration of MHA plate whose
culture results do not show any growth of bacterial
colonies.
BROMO 2018 - Bromo Conference, Symposium on Natural Products and Biodiversity
2

3
Table 1. Result of MIC test of Leaf Jackfruit Leaf Extract (Artocarpus heterophyllus Lam.) on MRSA bacteria.
Treatment
Concentration
Result
(Turbidity [+]; Clear [-])
Positive control
-
+
Negative control
-
-
A. heterophyllus
1280 µg/ml
-
A. heterophyllus
640 µg/ml
-
A. heterophyllus
320 µg/ml
-
A. heterophyllus
160 µg/ml
+
A. heterophyllus
80 µg/ml
+
A. heterophyllus
40 µg/ml
+
A. heterophyllus
20 µg/ml
+
A. heterophyllus
10 µg/ml
+
A. heterophyllus
5 µg/ml
+
A. heterophyllus
2,5 µg/ml
+
A. heterophyllus
1,25 µg/ml
+
A. heterophyllus
0,625 µg/ml
+
Positive control = sterile BHI and MRSA bacterial inoculum; Negative control = BHI sterile
3 RESULT AND DISCUSSION
The experiments performed by finding MIC and
MBC value of jackfruit leaf extract (Artocarpus
heterophyllus Lam.) against MRSA bacteria in vitro.
The research was conducted by broth macrodilution
method . The extract used was a crude extract in a
DMSO solvent with a potential of 100,000 μg / mg
obtained from LIPI, a total volume of ± 235 μL
extract. Based on research that has been done,
obtained MIC jackfruit leaf extract to MRSA bacteria
of 320 μg/ml and MBC of 1280 μg/ml. In this
experiment we found different turbidity levels on test
tubes after incubation for 1x24 hours. Basically, the
addition of stock extract on sterile BHI will produce
a turbid liquid. Nevertheless, the researchers
compared the turbidity of each tube with positive
control and negative control. The tubes contain a
jackfruit leaf extract in a serial concentration of 0.625
μg/ml to 160 μg/ml were having similar turbidity with
positive controls (BHI and MRSA bacteria without
extract). Meanwhile, tubes containing jackfruit leaf
extract with concentrations of above than 320 μg/ml
resulting clearer turbidity. The results obtained can
be seen in the table 1.
Cultures on MHA medium were carried out to
confirm the results of MIC and determine the MBC.
In this experiment, culture of MHA medium was
performed for all extract concentrations. The results
of culture can be seen in the figure 1.
MBC is the lowest concentration in which no
bacterial colony growth is found in culture. Thus, the
MBC for jackfruit leaf extract (Artocarpus
heterophyllus Lam.) is 1280 μg/ml.
In addition, tubular macrodilution testing was also
performed to determine MIC and MBC vancomycin
against MRSA bacteria. In this study vancomycin
antibiotics were used as a comparison. From the
results of MIC and MBC vancomycin tests on MRSA,
2 μg/ml result was obtained for both. Based on the
Clinical Laboratory Standards Institute (CLSI), there
are three classifications of S. aureus based on their
susceptibility to vancomycin, ie sensitive (<2 μg/ml),
intermediates (4-8 μg/ml), and resistant (> 16 μg/ml)
. Thus it can be concluded that the MRSA used in this
study is sensitive to vancomycin.
Test method of jackfruit leaf extract in
macrodilution was chosen because the result obtained
is quantitative, that is by finding MIC and MBC. The
macrodilution method is less used than the disc
diffusion method. However, with the consideration
that the extract is a crude extract that still contains
solids material and easily settles, it is feared the
extracts are not spread evenly if the researchers use
disc diffusion method.
In Vitro Antibacterial Activity Test of Jackfruit (Artocarpus heterophyllus Lam.) Leaf Extract against Methicillin-Resistant Staphylococcus
aureus (MRSA)
3
4
However, the weakness of the macrodilution
method is manual preparation that often occurs errors,
requiring more places and reagents, and generally
MIC or MBC is found to be the range between the
lowest concentrations with no bacterial colonies and
the nearest concentration below (Jorgensen JH et al,
2009).
In this study, we used dimethylsulfoxide (DMSO)
as a solvent of jackfruit leaf extract. DMSO is a very
polar liquid that is generally used as a solvent. DMSO
was chosen because it does not affect the antibacterial
activity of the extract. Another study show that
DMSO has bacterial inhibition but is weaker than
methanol or ethanol (the solvent commonly used to
dissolve the extract), so the use of DMSO is more
recommended (Wadhwani T et al, 2008).
Jackfruit (Artocarpus heterophyllus Lam.) Has
active ingredients, ie phytosterol and terpenoids.
Jackfruit leaves contain flavonoids, terpenoids,
steroids, phenols, glycosides, and saponins
(Sivagnanasundaram P et al, 2015). Jackfruit leaf
extraction with silver nitrate can also produce silver
nanoparticles (Thombre R et al, 2012). These active
ingredients are believed to have antibacterial and
antioxidant effects. The content of the active
ingredient in jackfruit leaves is consistent with the
results of a study conducted by Thombre et al. which
shows that the use of jackfruit leaf extract can inhibit
the growth of Escherichia coli, Bacillus subtilis and
Staphylococcus aureus with inhibition zones of 20
mm, 20 mm, and 17 mm, respectively. The zone of
inhibition was obtained by adding 20 μL of extract
with concentration of 40000 μg/ml into each diffusion
well.
In this study the obtained concentration of
jackfruit leaf extract is smaller to inhibit bacteria
compared with the concentrations obtained from
research Thombre, et al. MIC jackfruit leaf extract
was obtained at concentration of 320 μg/ml and MBC
at a concentration of 1280 μg/ml. This difference may
be due to Thombre, et al in his research specifies the
active substance used, ie only using silver
nanoparticles. While in this study the extract used is
a whole extract without extraction or separation of
further compound fractions. There may be
contributions from other antibacterial substances
other than silver nanoparticles in jackfruit leaf extract
used by researchers, so the use of the required
concentration becomes smaller to obtain MBC.
Until now, vancomycin is still the preferred
antibiotic for MRSA infections. Based MIC and
MBC values, there is a considerable concentration
difference between vancomycin and jackfruit leaf
extract against MRSA bacteria. Vancomycin has MIC
and MBC = 2 μg/ml, while jackfruit leaf extract has
MIC = 320 μg/ml and MBC 1280 μg/ml. This may be
due to differences in the mechanism of vancomycin
or jackfruit leaf extract in inhibiting growth or killing
MRSA bacteria.
In this study, we use crude extract of jackfruit leaf
which not yet purified for its active compound
towards MRSA or other bacteria, yet may become
one of the reason of high value of MIC and MBC.
Other active compound of jackfruit against MRSA
can be further analyzed as Manuel NV et al, 2012
found substance artocarpesin is the main compound
against MRSA, Furthermore, our MIC and MBC is
relatively low compare to study performed by Jha S
et al, 2013 which obtain 1.55-5.20 mg/ml of MIC
towards Escherichia coli, Pseudomonas aeruginosa
and Staphylococcus aureus bacteria.
However, with increasing MRSA resistance to
various antibiotics including vancomycin (Tenover
FC et al 2006), the use of jackfruit leaf extract as an
alternative antibiotic for MRSA infections may be
considered.
Figure 1. The results of the culture of jackfruit leaf extract (Artocarpus heterophyllus Lam.) With MRSA Bacteria on Mueller-
Hinton Agar medium. At concentrations of 0.625 μg/ml extract, 1.25 μg/ml, and so on up to 320 μg/ml there is a solid colony
growth that can not be counted. In extracts with concentrations of 640 μg/ml there is still a growth of 22 colonies of bacteria.
BROMO 2018 - Bromo Conference, Symposium on Natural Products and Biodiversity
4

5
While in the extract with a concentration of 1280 μg/ml no bacterial growth of MRSA was found.
4 CONCLUSION
Based on our study, jackfruit leaf extract is having
anti MRSA properties with MIC and MBC value
were 320 μg/ml and 1280 μg/ml respectively.
ACKNOWLEDGEMENTS
Publication of this was study supported by Hibah
PITTA UI 2018/2019.
REFERENCES
Brooks GF, Carroll KC, Butel JS, Morse SA,
Mietzner.Jawetz, Melnick, &Adelberg‟s.,(2016).
Medical microbiology. 27th ed. California: McGraw-
Hill, Chapter 13
Departemen Kesehatan RI. (2010). Buletin penyakit tidak
menular. Jakarta: Kementerian Kesehatan RI, form:
http://www.depkes.go.id/download.php?file=downloa
d/pusdatin/buletin/buletin-ptm.pdf.
Jha S, Srivastava AK., (2013). Screening of antibacterial
activity of the essential oil from seed of Artocarpus
heterophyllus. International Journal of Education and
Research: 1(1): 1-3.
Jorgensen JH, Ferraro MJ., (2009). Antimicrobial
susceptibility testing: a review of general principles and
contemporary practices. Medical Microbiology, 49:
1749-55.
Manuel NV, Osvaldo SD, Alejandra RT, Rodolfo A, Lucila
A., (2012). Antimicrobial activity of artocarpesin from
Artocarpus heterophyllus Lam. against Methicillin-
resistant staphylococcus aureus (MRSA). Journal of
Medicinal Plants Research, 6(34): 4879-82.
Mardiastuti HW, Karuniawati A, Kiranasari A, Ika Ningsih,
Kadarsih R., (2007). Emerging resistance pathogen:
situasi terkini di Asia, Eropa, Amerika Serikat, Timur
Tengah dan Indonesia. Majalah Kedokteran Indonesia:
57(3): 75-9.
National Institute of Allergy and Infectious Diseases.,
(2008). Methicillin-resistant Staphylococcus aureus
(MRSA): history [Internet]. 2008 Mar 4 [cited 2015 Jul
16]. from:
http://www.niaid.nih.gov/topics/antimicrobialResistan
ce/Examples/mrsa/Pages/history.aspx
National Tropical Botanical Garden. Artocarpus
heterophyllus [Internet]., (2015). [cited 2015 Jul 16].
from:
http://www.ntbg.org/plants/plant_details.php?plantid=
1219
Nurkusuma D., (2009). Faktor yang berpengaruh terhadap
Methicillin-resistant Staphylococcus aureus (MRSA)
pada kasus infeksi luka pasca operasi di ruang
perawatan bedah Rumah Sakit Dokter Kariadi
Semarang [Thesis]. Semarang: Universitas
Diponegoro.
Sivagnanasundaram P, Karunanayake KOLC., (2015).
Phytochemical screening and antimicrobial activity of
Artocarpus heterophyllus and Artocarpus altilis leaf
and stem bark extracts. OUSL Journal; 9: 1-17.
Tenover FC. Mechanism of antimicrobial resistance in
bacteria., (2006). The American Journal of Medicine:
119(6A): S3-10.
Thombre R, Parekh F, Lekshminarayanan P, Francis G.,
(2012). Studies on a antibacterial and antifungal
activity of silver nanoparticles synthesized using
Artocarpus heterophyllus leaf extract. Biotechnol.
Bioinf. Bioeng; 2(1): 632-7.
Orwa, et al., (2009). Artocarpus heterophyllus.
Agroforestry Database 4.0, World Agroforestry.
Wadhwani T, Desai K, Patel D, Lawani D, Bahaley P, Joshi
P, et al., (2008). Effect of various solvents on bacterial
growth in context of determining MIC of various
antimicrobials. The Internet Journal of Microbiology;
7(1): 1-6
In Vitro Antibacterial Activity Test of Jackfruit (Artocarpus heterophyllus Lam.) Leaf Extract against Methicillin-Resistant Staphylococcus
aureus (MRSA)
5
